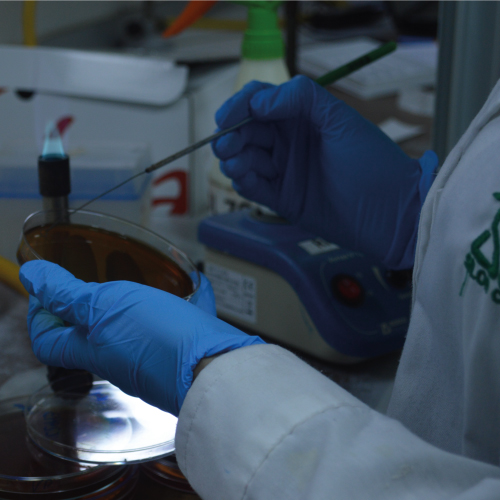
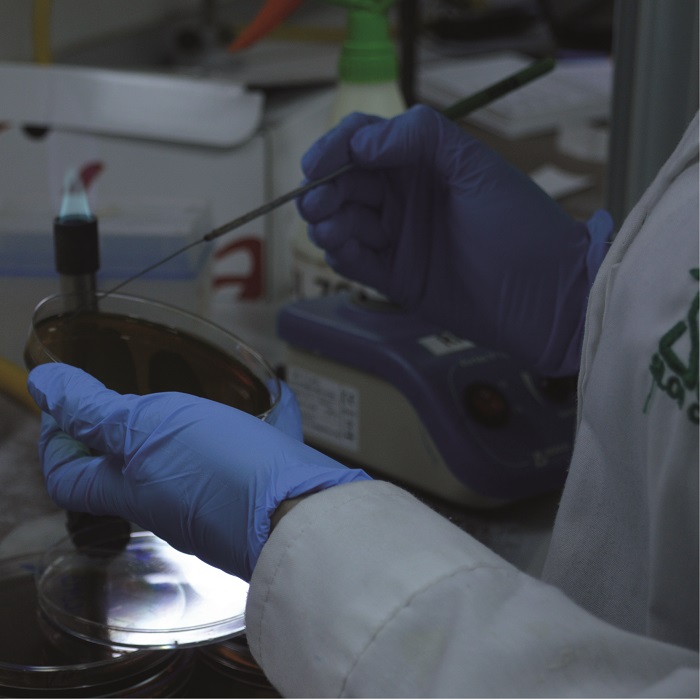

Acerca de nosotros
Somos los Mejores
Silob Chile Ltda. Es una empresa privada de la Región de Valparaíso, con alcance en todo Chile y con más de 30 años de experiencia. Prestamos servicios de muestreo y análisis para actividades productivas o de servicios, públicos o privados Silob Chile realiza muestreo y ensayos microbiológicos, físico químicos y organolépticos en Alimentos, Productos Hidrobiológicos, Aguas, Aguas Residuales y sedimentos acreditados bajo la NCh ISO 17025.Of2005 Además Silob Chile cuenta con un organismo de inspección acreditado por el INN bajo la NCh17020:2012.
Silob Chile, cuenta con modernos equipos de ultima generación, como el nuevo ICP 7700 que esta configurado para análisis de aguas, sedimentos, lodos, alimentos, riles y productos hidrobiológicos. Equipos de PCR que detecta salmonella spp, Listeria monocytogenes y/o Escherichia coli en alimentos y superficies en sólo en 48 horas.
Conozca
Nuestros Servicios
Nuestro laboratorio microbiológico dispone de 30 años de experiencia en análisis de microrganismos indicadores de higiene y patógenos en: Alimentos, Productos hidrobiológicos, Aguas, Aguas residuales y Sedimentos. Muestras ambientales (superficies, manipuladores, ambiente)
Dentro de los indicadores y patógenos más evaluados se encuentran:
Recuento Coliformes Totales (NMP/100ml)
Recuento Coliformes Fecales (NMP/100ml)
Listeria monocytógenes
Salmonella
Escherichicia coli
E coli O157H7
Campylobacter
En esta área nuestra empresa dirige todos sus esfuerzos en los análisis Físicos, Químicos y Microbiológicos aplicables a aguas de tipo potable, industriales, de riego y de recreación. Para esto SILOB CHILE se rige por las normas chilenas editadas por el Instituto Nacional de Normalización, las normas indicadas por la Superintendencia de Servicios Sanitarios, las del Standard Methods for the Examination of Water and Wastewater, APHA, AWWA, EPA, etc.
Determinación Sólidos Totales
Determinación Sólidos Disueltos Totales
Determinación Sólidos Suspendidos Totales
Determinación Sólidos Sedimentales
Determinación Demanda Bioquímica de Oxígeno (DBO5)
Determinación Demanda Química de Oxígeno (DQO)
Determinación Grasas y Aceites
Determinación Hidrocarburos
Determinación Arsénico
Determinación Metales
Determinación de Cromo Hexavalente
Determinación de Cromo Total
Determinación de Mercurio
Determinación de Cianuro
Determinación de Fósforo
Determinación de Nitrógeno (Nitrógeno total, orgánico, amoniacal, nitritos y nitratos).
Determinación de Sulfato
Determinación de Fenol
Determinación de Detergentes
Determinación de Oxígeno Disuelto
Determinación de Cloruros
Determinación de Alcalinidad
Determinación de Flúor
Determinación de Salinidad
Determinación Triclorometano
En esta área nuestra empresa dirige todos sus esfuerzos en los análisis Físicos, Químicos y Microbiológicos aplicables a aguas de tipo potable, industriales, de riego y de recreación. Para esto SILOB CHILE se rige por las normas chilenas editadas por el Instituto Nacional de Normalización, las normas indicadas por la Superintendencia de Servicios Sanitarios, las del Standard Methods for the Examination of Water and Wastewater, APHA, AWWA, EPA, etc.
Muestreo Acreditado
Estamos acreditado para muestreos de Producto hidrobiológicos para análisis microbiológico, físico químico y organoléptico muestreo acreditado según NCh ISO 17025.Of2005 y según NCh ISO 17020:2012 Alimentos : Para análisis microbiológico y químico Aguas: para análisis microbiológico y físico químico convenio Sernapesca, SISS y en vías de acreditar convenio con la SMA Superficies manipuladores y ambiente para análisis microbiológico muestreo acreditado según NCh ISO 17025.Of2005 y según NCh ISO 17020:2012
Silob Chile ha acreditado con el INN bajo la NCh-ISO 17020:2012 su organismo de inspección (OI), para muestreo de ensayos químicos, microbiológicos, físico organolépticos y bioensayos para productos hidrobiológicos (OI 113), muestreo mediciones y pruebas para ensayos físico-químicos, físico-organoléptico y microbiológico de aguas (OI114); muestreo para ensayos microbiológicos de utensilios, superficies, manipuladores y ambiente (OI115)
Acreditaciones
Revisa Nuestras Acreditaciones
Contactenos
Oficinas y Departamentos
-
Silob Valparaíso
Javiera carrera 839 Cerro Placeres, Valparaíso Fono(56-322498177 - 56-322189000) contacto@silobchile.cl -
Silob Santiago
Guardia Vieja 255 Of. 1501 Providencia, Santiago Fono (56-2) 23319550 silobstgo@silobchile.cl -
Silob Puerto Montt
Benavente 315 oficina 305 Puerto Montt Fono. (56-65) 2222602 silobpuertomontt@silobchile.cl
-
Alexandra Lobos, Gerente de calidad
Mail: alobos@silobchile.cl -
Silvia Díaz, Encargada Laboratorio de Aguas
Mail: s.diaz@silobchile.cl -
Francisca Quiroz, Encargada Laboratorio Alimentos
Mail: fquiroz@silobchile.cl -
Isabel Consigliere, Encargada Laboratorio Hidrobiológico
Mail: iconsigliere@silobchile.cl -
Jorge Peñaloza, Coordinador de muestreo aguas y riles
Mail: ambiental@silobchile.cl